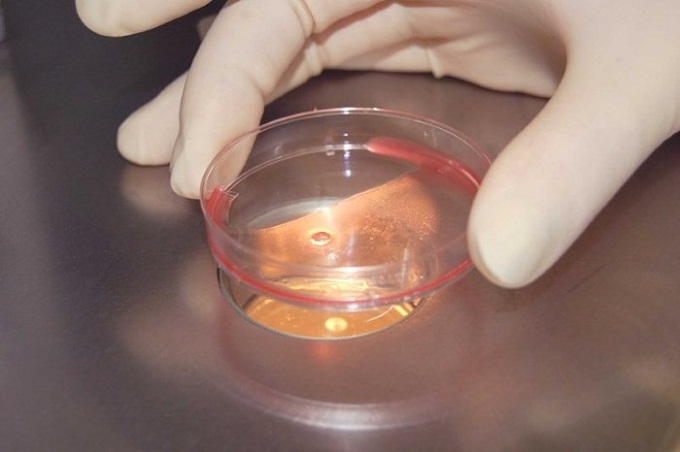

В Черкесске суд решает судьбу эмбрионов
Год назад семейная пара из Черкесска прибегла к экстракорпоральному оплодотворению, но беременность не наступила. При этом остались неиспользованными еще шесть эмбрионов. Теперь супруги развелись и с помощью суда пытаются решить судьбу эмбрионов, сообщает Интерфакс.
Бывший супруг настаивает, что необходимо все уничтожить, а жена требует эмбрионы оставить.По мнению наблюдателей, разбирательство в Черкесском городском суде будет долгим и, скорее всего, пройдет все ступени обжалования.
Как считают независимые юристы, дело может дойти до того, что мужчине придется платить алименты, если, конечно, когда-нибудь хоть из одного эмбриона разовьется ребенок.
Тем временем суд пока запретил утилизацию эмбрионов, они арестованы до вынесения окончательного решения по делу.
0
0
Если вы заметили ошибку, выделите необходимый текст и нажмите Ctrl+Enter или Отправить ошибку, чтобы сообщить об этом редакции.
Читайте также

В Украине «духовника Трампа» заверили в религиозной свободе
31 Марта 2025 11:48

Братия лавры поздравила митрополита Павла с 31-летием служения наместником
31 Марта 2025 09:54

Амстердам: Вторжение в пещеры Лавры – возврат к советским преследованиям
31 Марта 2025 09:15

Более 20 стран ЕС осудили Венгрию за запрет пропаганды ЛГБТ среди детей
30 Марта 2025 18:15

Блаженнейший возглавил хиротонию епископа Раховского
30 Марта 2025 13:35

Митрополит Виктор: Больно, что мощи лавры превращают в объект для опытов
30 Марта 2025 12:49






